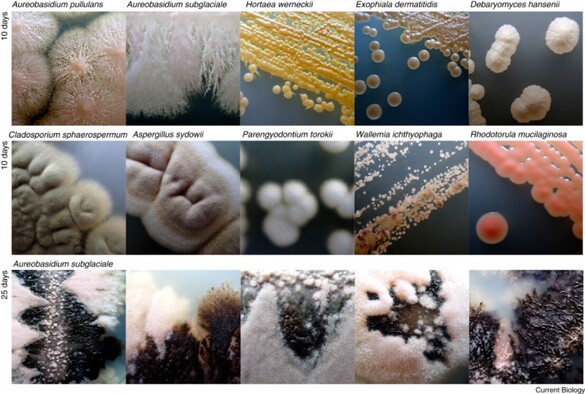

Jason Stajich · @hyphaltip
284 followers · 193 posts · Server genomic.socialReposting from @extremefungi: Our Current Biology Primer on #fungi from extreme environments just came online!
Free access for the next 50 days: authors.elsevier.com/a/1hTUb3QW8S2Q…
#extremefungi #extremophiles
#fungi #extremefungi #extremophiles
ISEP · @isep
21 followers · 10 posts · Server mstdn.scienceNew #ISEPpapers! Enchelyothrix muria n. gen, n. sp., (#Ciliophora, Litostomatea, Spathidiida), an extreme halotroph spathidiid from #MaharlooLake, #Iran: Mahnaz Barmshuri et al. https://www.sciencedirect.com/science/article/pii/S0932473923000500 #protists #ciliates #microbes #NewSpecies #microorganisms #halophiles #extremophiles
#iseppapers #ciliophora #maharloolake #iran #protists #ciliates #microbes #newspecies #MicroOrganisms #halophiles #extremophiles
Sterling Ericsson · @sterlingericsson
146 followers · 153 posts · Server mstdn.scienceAsbestos has long been the retroactive bane of building constructors and environmental engineers alike, due to contamination and spread.
Now, University of Pennsylvania scientists have found that extremophiles such as D. palaeochoriense are able to break down the iron in asbestos through anaerobic respiration and reduce its toxicity massively.
#Asbestos #Environment #Toxicity #Contamination #Bioremediation #Science #Biology #Extremophiles #Microbiology #Scicomm
#asbestos #environment #toxicity #contamination #bioremediation #Science #biology #extremophiles #microbiology #scicomm
CellBioNews · @cellbionews
38 followers · 887 posts · Server scientificnetwork.deThe #genetics of #temperature adaptation: How does life thrive in extreme conditions?.
https://phys.org/news/2023-03-genetics-temperature-life-extreme-conditions.html
#genetics #temperature #extremophiles #proteomics
The Kid Should See This 🌈🪐✨ · @tksst
204 followers · 143 posts · Server universeodon.com👽👀🦠 https://thekidshouldseethis.com/post/panspermia-alien-life-bbc-ideas-video
Learn about different kinds of #microbes and #extremophiles, as well as some of the relatively recent interplanetary discoveries that help make #panspermia—a concept that suggests life may have been seeded between our local #planets or throughout the #universe through #meteorite impacts, #interstellar dust, or other #space debris—a credible hypothesis.
#video #space #aliens #science
#astrobiology #bbc #comets #microbiology #bacteria #ufo
#microbes #extremophiles #panspermia #planets #universe #meteorite #interstellar #Space #video #aliens #Science #astrobiology #bbc #comets #microbiology #bacteria #ufo
Dr Adrienne Kish · @AdrienneKish
50 followers · 7 posts · Server mstdn.science🚨 Now out in Frontiers in Microbiology (Extreme Microbiology) : PhD candidate Charly Favreau & the rest of our team of collabs present new methods for proteomics of #halophiles in halite to show how Halobacterium acclimates to survival inside halite brine inclusions #extremophiles
https://www.frontiersin.org/articles/10.3389/fmicb.2022.1075274/full
This is a 1st article for Charly Favreau & Marie Marugan, featuring the work of Alicia Tribondeau (defending her PhD in 2 weeks) #proudPImoment #NextGenerationOfExtremophileResearchersIsHere
#halophiles #extremophiles #proudpimoment #nextgenerationofextremophileresearchersishere
The Kid Should See This 🌈🪐✨ · @tksst
89 followers · 40 posts · Server universeodon.com🌲🕰 https://thekidshouldseethis.com/post/methuselah-bristlecone-pine-tree-5000-years-old-minuteearth
Methuselah, a #tree that has lived 5,000 years... but how?
#tree #video #age #Science #biology #extremophiles
Caroline P · @Caro
14 followers · 1 posts · Server ecoevo.socialHi everyone - here is my #introduction - I am an environmental microbiologist interested in #extremophiles, #soilmicrobiomes and how vegetation fires and climate change affect microbiomes.
I am also vegan, love mountaineering and I am worried about the climate crisis.
#introduction #extremophiles #soilmicrobiomes
Sabina Atl · @AtlSabina
3 followers · 3 posts · Server mastodon.sdf.orgLast week I presented my work at the International Workshop at the Mexican Network of #Extremophiles 🌊🍄
I study how the coral's mycobiome react to the Stony Coral Tissue Loss Disease.
I would love to meet some #marine #mycologists! Feel free to reach out 😁
#extremophiles #marine #mycologists
Dr Adrienne Kish · @AdrienneKish
38 followers · 4 posts · Server mstdn.scienceAs I am making the transfer here, let me give a quick #introduction - I'm here to enjoy engaging and engaging about #extremophiles #microbiology #archaea #astrobiology #exobiology #disabledinSTEM #academicchatter #STEM #PhDmentoring #ECRchat
#introduction #extremophiles #microbiology #archaea #astrobiology #exobiology #disabledinSTEM #academicchatter #STEM #PhDmentoring #ecrchat
Ron Masse · @Ron_masse
44 followers · 56 posts · Server fediscience.org#synbio #syntheticbiology #secondarymetabolites #amr #drugdiscovery #MicrobialEcology #MicrobialGenomics #organicchemistry #chemistry #genomics #fungus #archaea #extremophiles #computationalbiology
#computationalbiology #extremophiles #archaea #fungus #genomics #chemistry #organicchemistry #MicrobialGenomics #MicrobialEcology #drugdiscovery #AMR #secondarymetabolites #SyntheticBiology #synbio
Tech News Worldwide · @TechNews
11307 followers · 97996 posts · Server aspiechattr.meWhy the Search for Life on Mars Is Happening in Canada’s Arctic
https://www.wired.com/story/why-the-search-for-life-on-mars-is-happening-in-canadas-arctic/
#planetaryscience #Science/Space #extremophiles #Astrobiology #EarthScience #wateronMars #LifeHack #Science #arctic #space #Mars
#planetaryscience #science #extremophiles #Astrobiology #EarthScience #wateronMars #lifehack #arctic #space #mars